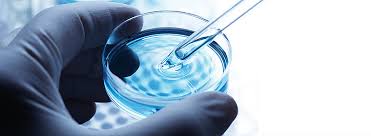

El Goldfish es un pez que se presenta en una gran cantidad de variedades, podemos encontrarlo con formas esbeltas y redondeadas, así mismo, tendremos colas alargadas y recortadas, incluso algunas variedades carecen de aleta dorsal, y, por si fuera poco, existe una gran variedad de características que los hacen totalmente llamativos y los reyes del acuario.
En los países latinoamericanos se han experimentado durante los último tres años, un crecimiento en las importaciones del pez dorado, poniendo a nuestra disposición peces que hace quince años eran imposibles de encontrar.
Con este auge, ahora tenemos acceso a peces realmente hermosos, las granjas del continente asiático pueden proveernos con peces desde una calidad apta para hobby, hasta una calidad digna de un campeón.
A mayor calidad el precio es mayor y el Goldfish no es la excepción
Así mismo, en Asia es posible encontrar una gran cantidad de “Groomers”, estas personas se dedican únicamente a criar peces de un alto grado de calidad, por lo que no se dedican a la reproducción ni a otra actividad dentro de la crianza de los peces dorados.
Los groomers seleccionan a sus ejemplares cuando son bebés, es decir, los eligen con una edad aproximada de 5 a 6 meses, en estos se busca el potencial de poder ser muy similar o igual al estándar de su variedad, debido a esto el desarrollo de alguna imperfección le deja fuera del plan de grooming.
Por lo normal, aquellos ejemplares que quedan fuera del plan, son vendidos a clientes con un alto nivel de exigencia, ya que, a pesar de haber desarrollado alguna imperfección, todavía son peces muy hermosos, los cuales estarían catalogados incluso como Grado Show.
Aquellos goldfish que completan el plan de grooming, son grandes contendientes en los concursos más importantes de su región, si llegan a ganar el concurso son subastados, en estas subastas se suelen ver personas que son dueños de granjas, hobbistas con un grado de exigencia alto y dueños de tiendas de Goldfish, estos peces terminan siendo catalogados como High End y suelen tener un precio promedio de 800 USD.
¿Te imaginas el orgullo de los groomers al criar tales bellezas?
No es un secreto, aquello que hiciste y alcanza destacar, te hace sentir orgulloso, feliz y satisfecho.
Afortunadamente, en la actualidad es posible hacer grooming a peces de un buen grado, esto se debe a que llega también Goldfish bebé, principalmente ryukin, ranchu y oranda.
¿Te unes al reto?
¿Cómo criar el Goldfish del que estarás orgulloso?
Para poder ayudarte a criar el Goldfish del que estarás orgulloso, tenemos que compartirte un plan para que puedas hacerlo, por primera vez se revela un secreto celosamente guardado por criadores, este está aquí y es solo para ti.
7 puntos que revisar al seleccionar Goldfish bebés
¿Ya sabes cuál es tu variedad favorita?
Bien, ahora lo que necesitas conocer es cómo seleccionar entre tantos peces que tendrás frente a ti, así que usa este checklist para guiarte:
1. Revisa que la profundidad del cuerpo sea más que la mitad de la longitud total.
2. Solamente debe de tener una aleta dorsal, en variedades sin aleta dorsal la espalda debe de estar limpia
3. Las aletas caudales, anales, pectorales y pélvicas deben estar en pares y ser del mismo tamaño
4. La aleta caudal y anal deben de estar totalmente divididas
5. La aleta caudal debe de ser más de ¾ la longitud total del cuerpo
6. Según la variedad revisar que tenga inicios de crecimiento del wen, ojos sobre salidos, bolsas de burbujas en crecimiento
7. Libre de enfermedades, parásitos y deformidades
Se podría incluir la coloración dentro de la selección, sin embargo, en esta edad los peces todavía no desarrollan su coloración final, por tal motivo la coloración no es posible evaluarla en este momento.
Es recomendable que uses una regla o cinta métrica para poder realizar las mediciones, de otra forma sería fácil equivocarte.

¿Qué prefieres, crecimiento de wen, desarrollo de cuerpo, aletas enormes?
Tómate todo el tiempo que sea necesario, si dudas es mejor dejarlo aún lado, para que puedas guiarte en la selección ten presente la imagen del pez que quieres lograr, por lo que deberás de buscar esas señales en los bebés, en caso de que los encuentres, tendrá el potencial para desarrollar las características que deseas.
Los siete puntos anteriores, son una base a partir de la cual podremos asegurar un Goldfish adulto, el cual estará equilibrado y proporcionado, además considerar la salud del pez, con esto tenemos una alta probabilidad de criar nuestro Goldfish ideal.
Por diferentes motivos que pudieran ocurrir en el transcurso del plan, lo recomendable es comprar un par como mínimo, aunque lo ideal sería comprar cinco ejemplares, de esta forma no se perderá el trabajo que hemos llevado a cabo.
¿Estás list@ para cuidar goldfish bebés?
Ahora que ya tienes a tus Goldfish bebés es momento de comenzar la crianza de estos, para lograrlo tendrás que poner parte de tu tiempo y esfuerzo en el cuidado, de una forma sencilla lograrás que estos peces dorados se desarrollen en su totalidad.
Calidad del agua
Una de las actividades a la que le damos una alta prioridad es el mantenimiento de la química del agua, mal llamada “calidad del agua”, la química del agua tiene la finalidad de ofrecer un ambiente confortable y seguro a los peces dorados.
La meta es tener un nivel máximo de 20 ppm (menor es deseable), en el caso del amonio deberá de ser cercano a 0, con un pH entre 7 y 8, en una temperatura del agua 22 °C – 26 °C ; así que deberás de conseguir estos tres test, en caso contrario de que desees hacer esto sin los test, estaremos agradecidos de que compartas tu experiencia.
Para poder mantener estable la química del agua, deberemos de hacer un cambio del 25 % cada tres días, o si lo prefieres un cambio del 50 % cada cuatro días, esto es totalmente libre a tu elección.
¿Qué hay sobre la cantidad de litros?
La regla de 40 litros por pez dependiendo de donde te pares puede ser aceptada o rechazada, en este caso no necesitamos un estanque de bajo mantenimiento.
Para este plan de crianza se recomiendan 100 litros desde dos peces hasta cinco peces.
¿Porqué nos negamos la regla de los 40 litros?, esta regla fue hecha para tener Goldfish en un acuario con un mínimo de mantenimiento, es decir, cambios de agua semanales, dos o tres veces de alimento al día y desarrollo mínimo de los peces.
En este plan de crecimiento se efectuarán cambios de agua cada tercer día, además deberá de retirarse el exceso de alimento, de esta forma tendremos un equilibrio logrado por un mantenimiento constante.
Alimentación
La alimentación deberá de ser rica en proteínas, el aporte de estas proteínas será con pellet y alimento vivo (se recomienda la artemia salina).
Los pellets deberán de contener al menos un 45 % de proteína, no te guíes solamente por el contenido de proteínas, cuida que el alimento sea de una muy buena calidad, este alimento se los darás de 4 a 5 veces al día.
Si elijes pellets con un bajo contenido de proteínas los peces no se desarrollarán al ritmo deseado, dietas con un 30 % de proteína son consideradas cuando ya no se encuentran en una etapa de desarrollo.
El alimento vivo lo suministrarás tres veces a la semana, puede ser en la noche o en la mañana.
Algo muy importante que no debes de olvidar es retirar el exceso de alimento.
¿Qué hay sobre las plantas acuáticas?, puedes complementar su alimentación con elodea y lenteja de agua, de esta forma su sistema digestivo estará activo.
Observación
La observación es muy importante, ya que deberás de evaluar el crecimiento y estado de salud de los peces.
Cada dos semanas deberás de medir la longitud de los peces, solamente mide el cuerpo, las aletas no cuentan en esta evaluación, de esta forma podrás contrastar si está funcionando el plan de grooming. En caso contrario se debe de ajustar la alimentación y la cantidad de cambios de agua.
Deberás revisar cuerpo y aletas, no deben de presentar anormalidades, de esta forma aseguras que los peces están en un buen estado de salud.
Este plan se deberá de efectuar por un máximo de 6 meses, el tamaño de estos peces deberá ser próximo al intervalo de 3.3 a 4 pulgadas en cuerpo, de esta forma tendremos un Goldfish saludable y jovial, además que nos permite evaluar si algunos ejemplares pueden pasar a una segunda etapa de grooming.
¿Cuál es la variedad que te gustaría groomear y desarrollar?





